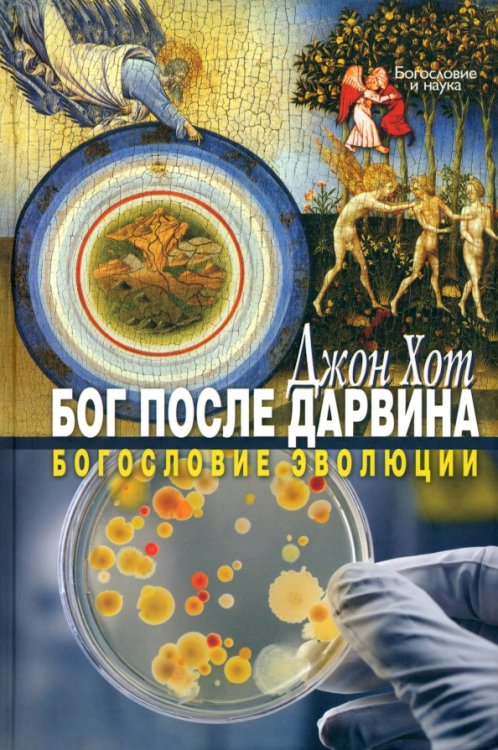
Бог после Дарвина. Богословие эволюции

Аннотация: Бог после Дарвина. Богословие эволюции
Замечательное исследование Джона Хота смело, не уклоняясь от сути вопроса, подходит к решению проблемы, которую создает эволюционный характер реальности для серьезной и интеллектуально глубокой веры в Бога. Эта книга полна удивительных догадок и озарений и может стать стимулом для мышления всех тех, кто серьезно интересуется полемикой между наукой и религией.
| Автор/составитель | Хот Джон |
| Серия | Богословие и наука |
| Год выпуска | 2011 |
| ISBN | 978-5-89647-242-1 |
| Производитель | ББИ |
| Издательство | ББИ |
| Количество томов | 1 |
| Количество страниц | 236 |
| Переплет | Твёрдый переплёт |
| Размеры | 218x145x15 мм |
| Цвет | Синий |
| Тип бумаги | офсетная (60-220 г/м2) |
| Формат | 60x90/16 (145x215 мм) |
| Стандарт | 18 |
| Вес | 344 |
| Область образования | религия |
| Тип материала | научные издания, теории |
| Язык | русский |


 Google
Google